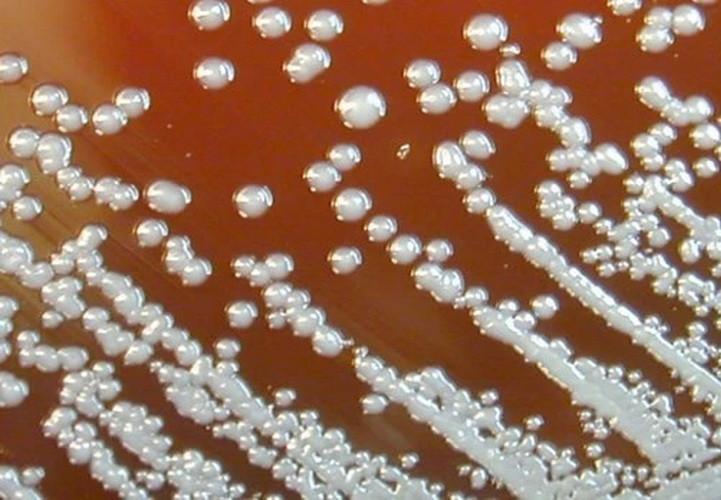
Vi khuẩn Burkholderia pseudomallei gây bệnh Whitmore. (Nguồn: CNN)

Ngày 5/4, ông Hoàng Hải Phúc, Giám đốc Trung tâm Kiểm soát bệnh tật tỉnh Đắk Lắk xác nhận, trên địa bàn vừa ghi nhận một trường hợp mắc bệnh Whitmore tại thành phố Buôn Ma Thuột.
Theo báo cáo của Trung tâm Kiểm soát bệnh tật tỉnh Đắk Lắk, bệnh nhân là P.Đ.V (sinh năm 1983, tại phường Tân Lợi, thành phố Buôn Ma Thuột), bị sốt kèm đau tức vùng lưng khoảng 20 ngày trước.
Ngày 30/3, bệnh nhân đi khám và nhập viện tại Bệnh viện Đại học Y dược thành phố Buôn Ma Thuột để điều trị. Đến ngày 4/4, bệnh nhân có xét nghiệm dương tính với vi khuẩn Burkholderia pseudomallei.
Cùng ngày, bệnh nhân được chuyển lên Bệnh viện Đa khoa vùng Tây Nguyên, tiếp tục điều trị với chẩn đoán áp xe lách, nhiễm trùng huyết do vi khuẩn Burkholderia pseudomallei. Hiện tại, bệnh nhân tỉnh, tiếp xúc tốt và đang được tích cực chăm sóc, điều trị.
Ngay sau khi ghi nhận ca bệnh, Trung tâm Kiểm soát bệnh tật tỉnh Đắk Lắk đã tiến hành điều tra, đồng thời thông báo thông tin ca bệnh cho Trung tâm Y tế thành phố Buôn Ma Thuột, hướng dẫn các biện pháp điều tra, xử lý môi trường.
Bệnh nhân là tài xế xe tải. Trong 21 ngày qua, bệnh nhân lái xe chở lợn từ Đắk Lắk đi Hà Nội và ngược lại, do đó, không rõ yếu tố dịch tễ. Điều tra tại nhà và các hộ dân xung quanh, ngành Y tế tỉnh không ghi nhận trường hợp mắc bệnh tương tự.
Trung tâm Kiểm soát bệnh tật tỉnh Đắk Lắk kiến nghị Viện Vệ sinh dịch tễ Tây Nguyên tiếp tục chỉ đạo chuyên môn kỹ thuật và hỗ trợ công tác xét nghiệm chẩn đoán trường hợp bệnh trên.
Sở Y tế tỉnh chỉ đạo các đơn vị y tế tăng cường giám sát, theo dõi, phát hiện các trường hợp nghi ngờ bệnh Whitmore; đồng thời, tuyên truyền đến người dân các biện pháp để chủ động phòng, chống bệnh.
Trung tâm Y tế thành phố Buôn Ma Thuột tiếp tục theo dõi tình hình dịch bệnh tại địa bàn, diễn biến dịch bệnh tại cộng đồng...
Bệnh Whitmore, còn gọi là vi khuẩn "ăn thịt người," là bệnh truyền nhiễm cấp tính do vi khuẩn có tên Burkholderia pseudomallei gây nên. Người nhiễm vi khuẩn Whitmore có tỷ lệ tử vong từ 40-60%, thường có dấu hiệu sốt cao, đau dạ dày, đau ngực, viêm mang tai (rất giống với quai bị), đau cơ khớp, đau đầu và co giật.../.
![[Infographics] Điều cần biết về bệnh truyền nhiễm nguy hiểm Whitmore](https://media.vietnamplus.vn/images/8cd58b0cafd4d1a4d26631f6fd7e1e817786c24e04a996306c7f4df521c63995cfb1b70bcffeabf074d0ad9cac95a519895134aa23e41c171975a1b94aae57a6fac3c8bbce0d98bc3914f5dc6cbea960/infographicswhitmore_2.jpg.webp)